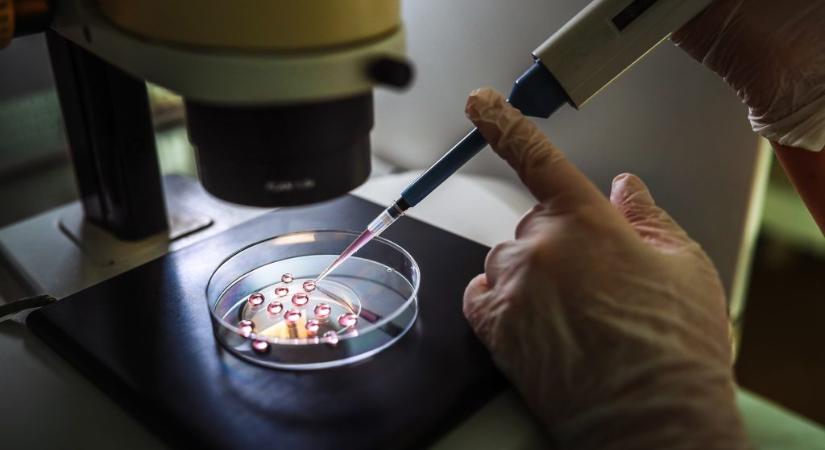
Kétszeres különbségek lehetnek egyes hazai lombikintézetek eredményessége között, megszereztük az adatokat

Kétszeres különbségek lehetnek egyes hazai lombikintézetek eredményessége között, megszereztük az adatokat
Az államosított intézeteket irányító Humánreprodukciós Igazgatóság azt állította, mindenütt ugyanolyan esélyei vannak a pácienseknek. A részletes adatok árnyaltabb képet mutatnak. Kétszeres különbségek lehetnek egyes hazai lombikintézetek eredményessége között, megszereztük az adatokat
- Hirdetés -